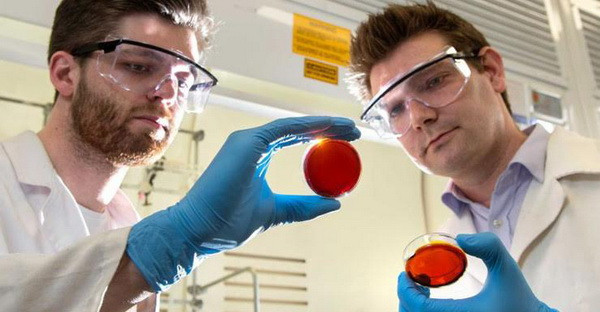
Tác dụng kỳ diệu mới của vỏ cam: Loại bỏ ô nhiễm thủy ngân ảnh 1

Hai nhà khoa học tìm ra phương pháp mới Max Worthington và Justin Chalker. (Nguồn: Daily News)
Hai nhà khoa học tìm ra phương pháp mới Max Worthington và Justin Chalker. (Nguồn: Daily News)
Theo News Daily, các nhà khoa học Australia vừa tình cờ phát hiện ra một phương pháp mới có thể loại bỏ thủy ngân ra khỏi nước bằng việc sử dụng một chất điều chế từ phụ phẩm của ngành công nghiệp và vỏ cam.
Trong khi các nhà khoa học chưa tìm ra phương pháp hữu hiệu rẻ tiền nào để loại bỏ thủy ngân ra khỏi nước biển thì đây là bước đột phá mới trong nghiên cứu nhằm loại bỏ ô nhiễm thủy ngân độc hại từ những nguyên liệu sẵn có với chi phí thấp.
Hai nhà khoa học tìm ra phương pháp này là Max Worthington và Justin Chalker thuộc trường Đại học Flinders, bang Nam Australia.
Nhóm nghiên cứu của hai nhà khoa học này đã kết hợp lưu huỳnh được tạo ra từ ngành công nghiệp hóa dầu và chất hydro carbon lỏng chưa bão hòa có vị chanh trong vỏ cam để tạo ra một loại cao su đỏ mềm và nó có thể hút thủy ngân từ trong nước.
Tiến sỹ Chalker cho biết nhóm nghiên cứu sử dụng hai chất này vì mỗi năm có tới 70 triệu tấn lưu huỳnh phụ phẩm của ngành công nghiệp dầu mỏ nhưng hầu như ít được sử dụng và 70 triệu tấn hydro carbon lỏng chưa bão hòa có vị chanh rẻ tiền từ ngành công nghiệp chế biến cam quýt.
Hiện các nhà nghiên cứu tiếp tục kiểm tra để bảo đảm chắc chắn rằng loại chất nhựa được tạo ra này không gây hại cho môi trường và hy vọng có thể sử dụng rộng rãi cũng như bán chất liệu mới này ra thị trường.
Tiến sỹ hóa học Chalker cho biết điều hữu ích nhất của nguyên liệu này là chúng rất rẻ và được tận dụng từ các sản phẩm phế thải. Có nghĩa rằng nó có thể được sử dụng rộng rãi trong làm sạch môi trường, phủ bên ngoài đường ống dẫn nước.
Ông Chalker cho rằng: "Nhiều khu vực trên thế giới bị nhiễm thủy ngân, ảnh hưởng tới nguồn cung cấp thức ăn và nước khiến cho việc tìm ra cách thức loại bỏ thủy ngân hữu hiệu và rẻ tiền là điều vô cùng cần thiết."
Đây là bước đột phá lớn vì thủy ngân hết sức nguy hiểm, có thể làm ô nhiễm thức ăn, nguồn nước, ảnh hưởng tới hệ thần kinh của con người và đặc biệt độc hại đối với trẻ em.
Theo báo cáo của Đại học Flinders, ô nhiễm thủy ngân xuất hiện như một hậu quả của một số ngành công nghiệp, trong đó bao gồm cả ngành khai mỏ và đốt cháy nhiên liệu hóa thạch.
Mức độ của chất gây ô nhiễm này đã tăng gấp 3 lần trong nước biển kể từ khi bắt đầu cuộc Cách mạng công nghiệp. Chất này nhiễm trong cá và hải sản, đi vào chuỗi thức ăn của con người từ đó dẫn tới các vấn đề về sức khỏe như giảm chỉ số thông minh ở trẻ em và giảm khả năng sinh sản của cá và chim.
Nghiên cứu này được đăng trên tạp chí Angewandte Chemie International Edition của Đức./.



































